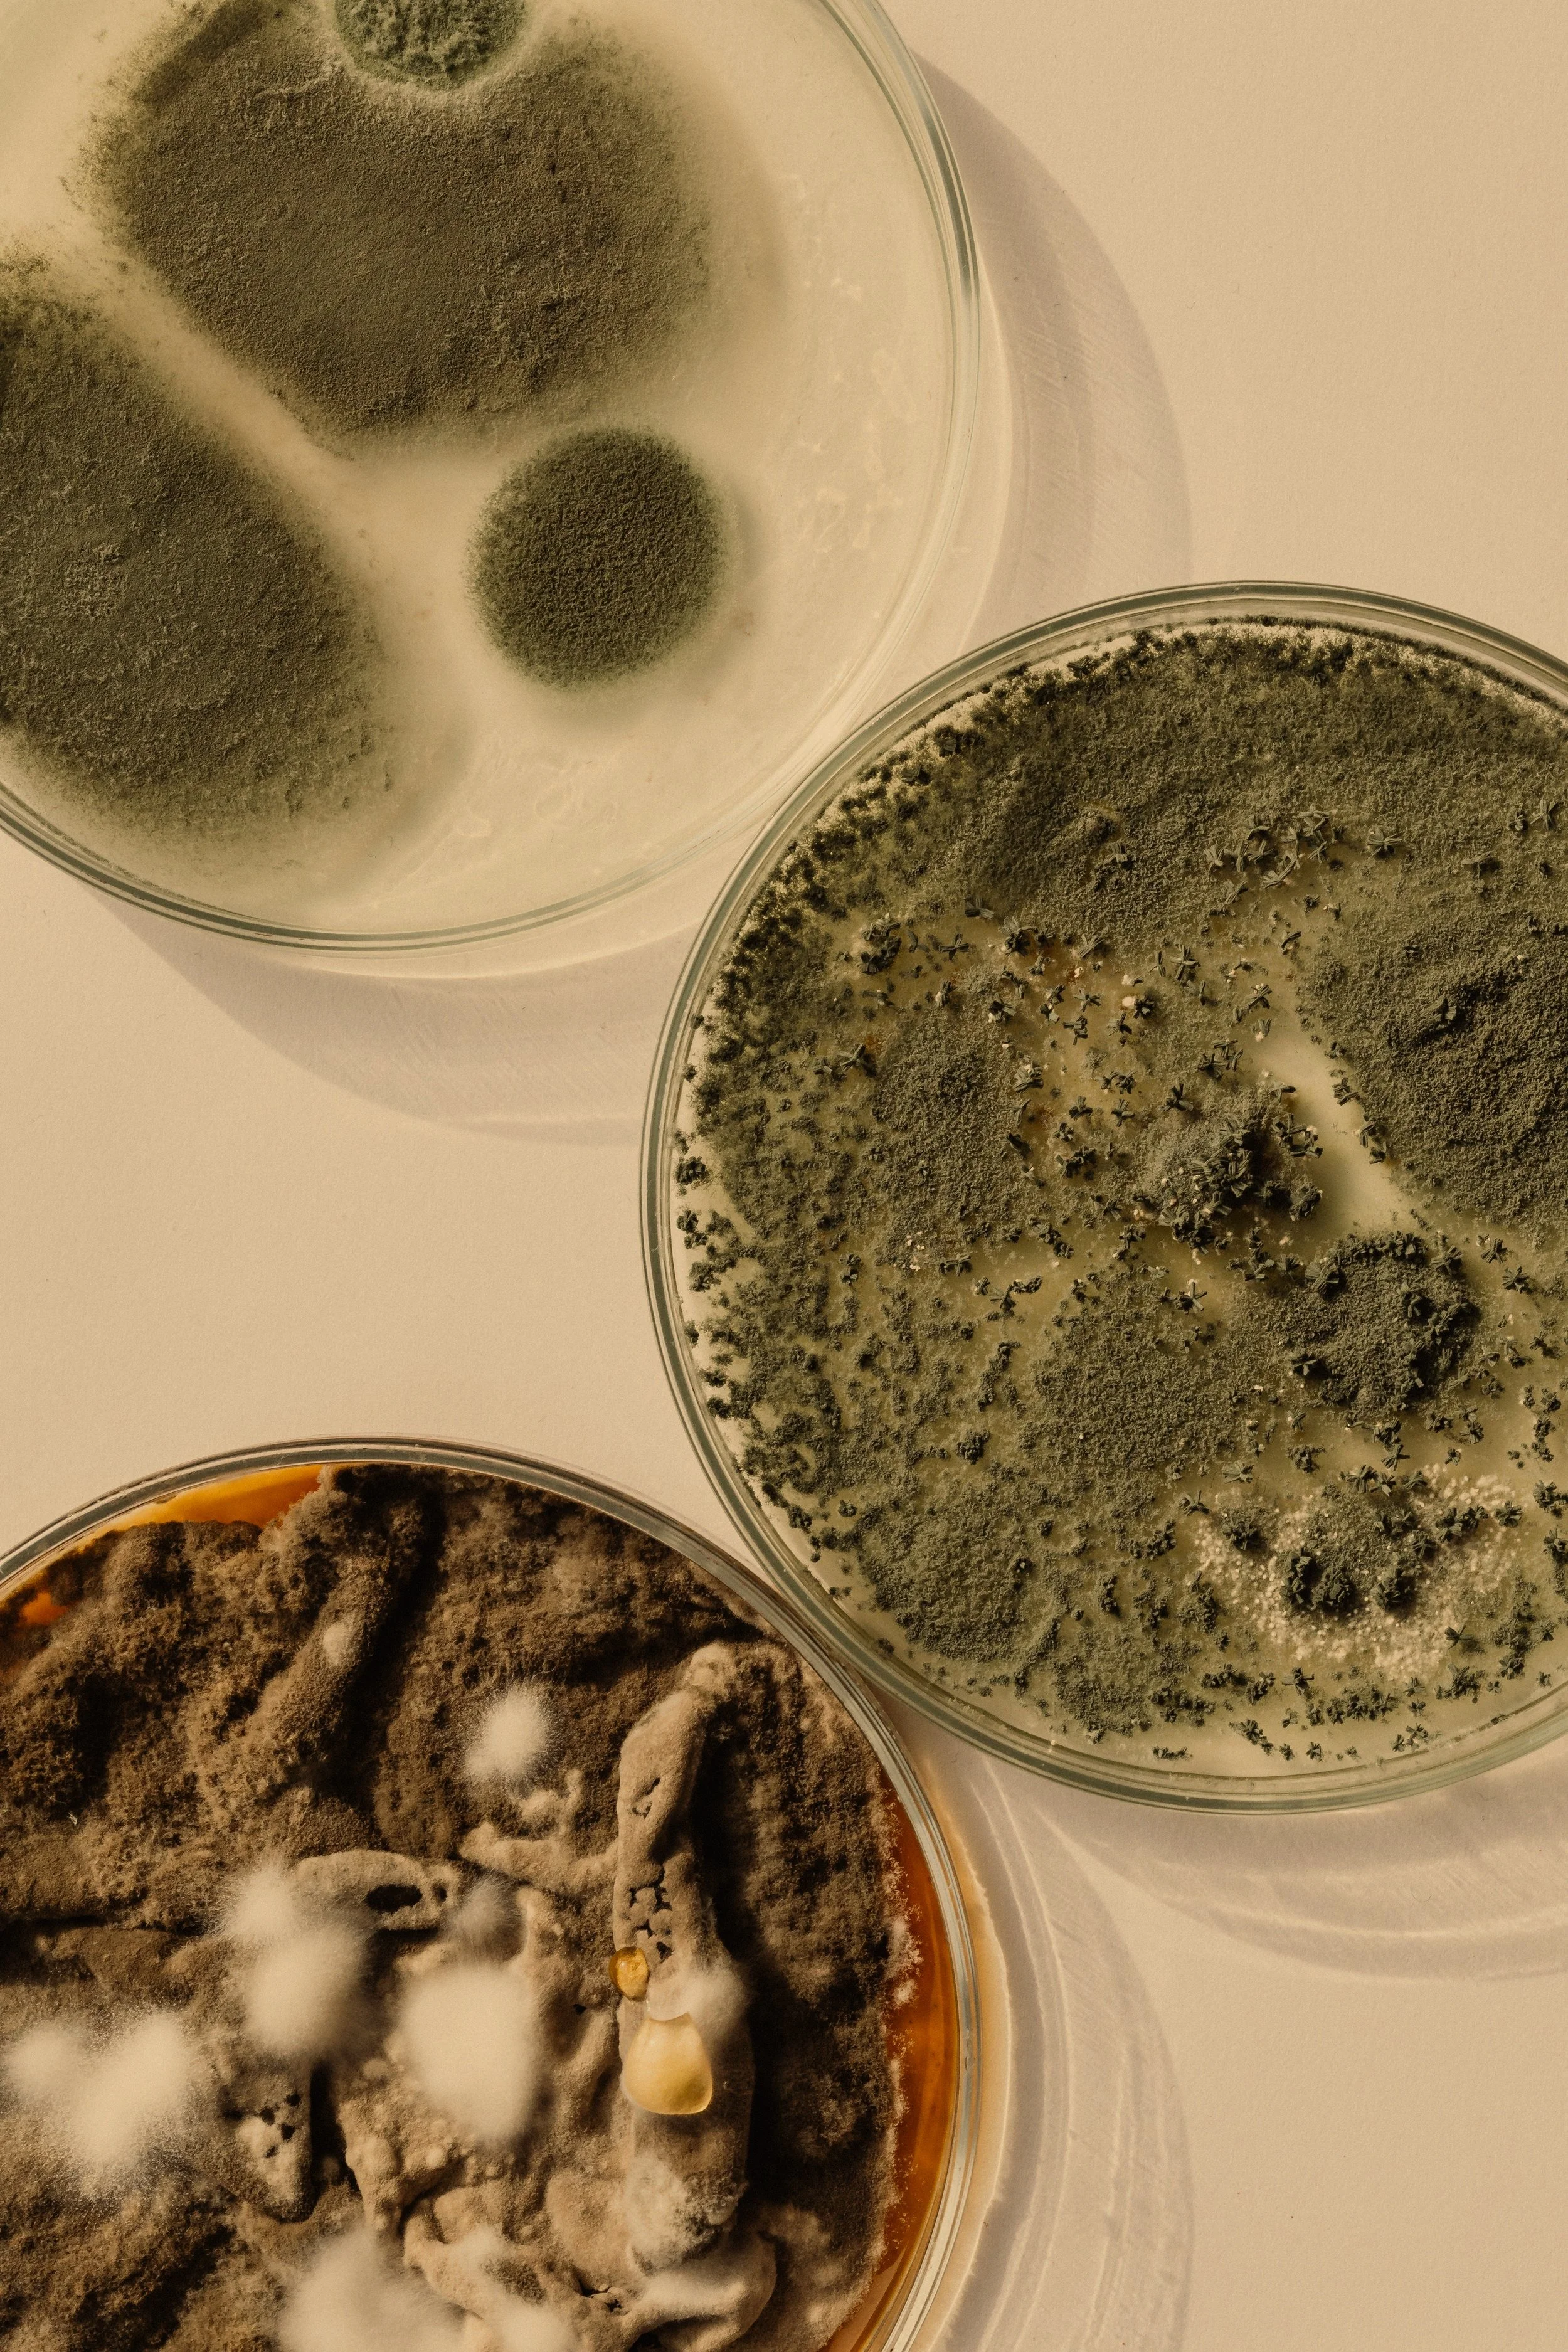

Our Services
Work With Exis
First, we dig into your health with the Intake & Case Review.
Then, you will pick the care that’s right for you.
Start Your Health Investigation Here
Initial Intake
The first step in your care journey. This 60 minute session is all about you, your story, your symptoms, and what hasn’t been working. we gather the full picture so nothing gets overlooked.
Comprehensive review of your health history
In depth symptom and lifestyle assessment
Space to share what’s been missed or dismissed
Lays the foundation for root cause care
Case Review
After your intake, we go behind the scenes to analyze your labs and clinical data. Then, in a second 60 minute session, we walk through everything together and build your personalized path forward.
Detailed lab interpretation and pattern recognition
Identification of underlying imbalances
Custom care plan designed just for you
Clear next steps to begin healing

Core Collective
Intake + Case Review required
-
Ongoing care built around you. After completing your initial intake and case review, this is where we continue your healing journey together, with support that evolves as you do.
-
Monthly 45 minute consultations
Functional lab monitoring & interpretation
Personalized nutrition, supplement, and lifestyle updates
Bi-Monthly progress check ins
Unlimited messaging access for questions between visits
Access to exclusive tools, education & wellness resources
Concierge scheduling & planning

Family Collective
Intake + Case Review Recommended
-
A compassionate, expert care plan designed for overwhelmed caregivers and their children. This plan supports up to three family members at a time, with flexibility to fit your household’s needs - for example:
Two adults and one child
One adult and two children
Additional family members can be added for a small monthly fee.
-
Monthly 30-45 minute consults per family member
Same week sick visits access
Personalized family wellness protocols and guidance
Unlimited messaging and portal access
Annual family wellness planning session
Supplement discounts and concierge scheduling
A one time initial intake and case review is recommended for each new participant but is not required.
Lab Interpretation + Consult
No Intake + Case Review Needed
-
Have labs from another provider but still feel like something’s missing? This one time session is designed to bring clarity to confusing results and help you connect the dots.
You desere more than “your labs look fine.” Let’s make sense of the data together and uncover what your body’s really trying to say.
-
30 minute consult to review your existing lab reports
Functional interpretation beyond standard “normal” ranges
Identification of patterns, imbalances, and potential root causes
Actionable guidance tailored to your unique health goals
How We Work Together
Complimentary Discovery Call
Your journey begins with a thoughtful, no pressure conversation. Whether you’re seeking support for yourself or for your child, this call is a space to share your concerns and ask questions. We’ll walk you through our process and explore whether Exis Health is the right fit for you.
Comprehensive Intake & Advanced Testing
Once we decide to move forward, you’ll complete a detailed intake that covers symptoms, history, lifestyle, and any previous diagnoses. If working with a child, we also take time to understand the full caregiving picture. Advanced lab testing may be recommended to uncover hidden imbalances. We’re not just guessing, we’re investigating.
Personalized Health Plan & Strategy
With your full story and labs in hand, we create a custom care plan that’s built around you (or your child’s) unique needs. Whether we’re supporting immune health, gut issues, inflammation, or something hard to name, we map out a strategy that’s both clinical and compassionate. Rooted in functional medicine and design to get to the “why”
Ongoing Partnership & Support
Healing takes time and you shouldn’t have to figure it out alone. We stay connected through follow ups, retesting when needed, and adjustments to your plan as your body responds. Behind the scenes there are hours that are spent reviewing your labs and tracking your process. Every decision is informed, intentional, and centered on long term healing.
